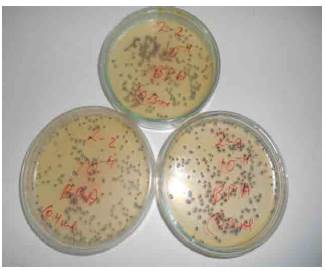
Untreated cotton fabric 130 g/m2.
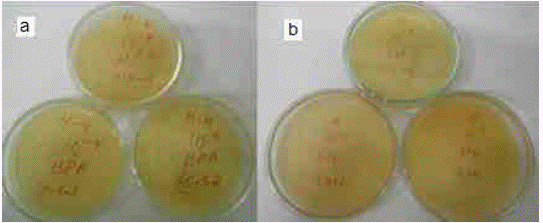
7. Treated cotton fabric (130 g/m2) a) concentration of 10 ppm, b) concentration of 20 ppm.

Artículos
Improvement of silver nonoporticle impregnation on cotton fabrics using o binder
Mejoramiento de la absorción de nanopartículas de plata en telas de algodón, utilizando un ligante
Melhoramento da absorção de nanopartículas de prata em tecidos de algodão, utilizando um ligante
Improvement of silver nonoporticle impregnation on cotton fabrics using o binder
Facultad de Ingeniería, vol. 26, no. 45, pp. 109-119, 2017
Universidad Pedagógica y Tecnológica de Colombia
Received: 30 September 2016
Accepted: 18 March 2017
Abstract: In this work, silver nanoparticles were synthesized by the polyol process, which reduces silver nitrate with ethylene glycol. The temperature effect and the polyvinylpyrrolidone (PVP) amount were studied. The temperatures used were 100, 120 and 140 °C. Three ratios of 0.00, 0.25, and 0.50 (% w/w) of PVP/AgNO3 were established. Nanoparticles with sizes less than 30 nm were obtained in conditions of 120 °C and 0.5 % w/w of PVP/AgNO3. Posteriorly, nanoparticles in concentrations of 10 and 20 ppm were deposited on cotton fabric by the pad-dry-cure technique, in order to analyze their bactericidal properties against the Gram positive bacteria Staphylococcus aureus 25923. The tests showed that cotton fabric with nanoparticles in concentrations of 10 and 20 ppm had good bactericidal properties, reducing bacterial colonies by over 98 %. Finally, a washing stability study of the fabrics impregnated with silver nanoparticles was performed, and an acrylic binder was added during the impregnation process. The results were obtained by bacteriological analyzes.
Keywords: Bactericidal Properties, Binder, Cotton, Silver Nanoparticles.
Resumen:
En este trabajo se sintetizaron nanopartículas de plata mediante el proceso de poliol, que reduce el nitrato de plata con glicol de etileno. Se estudió el efecto de la temperatura y la cantidad de polivinilpirrolidone (PVP). Las temperaturas utilizadas fueron 100, 120 y 140 °C. Se establecieron tres relaciones: de 0.00; 0.25 y 0.50 (% w/w) de PVP/AgNO3. Las nanopartículas con tamaños menores de 30 nm se obtuvieron en condiciones de 120 °C y 0.5 (% w/w) de PVP/AgNO3 Las nanopartículas obtenidas en concentraciones de 10 y 20 ppm fueron luego depositadas en telas de algodón, mediante la técnica "pad-dry-cure" (tela curada y seca), a fin de analizar sus propiedades contra la bacteria Gram positiva Staphylococcus aureus 25923. Las pruebas mostraron que las telas de algodón con una concentración de 10 y 20 ppm tenían buenas propiedades bactericidas, debido a la reducción de las colonias de bacterias por encima del 98 %. Finalmente, se llevó a cabo un estudio de estabilidad del lavado de las telas impregnadas con las nanopartículas de plata, y, además, se utilizó un ligante acrílico durante el proceso de impregnación. Los resultados se obtuvieron mediante análisis bacteriológicos.
Palabras clave: Algodón, Bactericidas, Ligante, Nanopartículas de plata.
Resumo:
Neste trabalho sintetizaram-se nanopartículas de prata mediante o processo de poliol, que reduz o nitrato de prata com glicol de etileno. Estudou-se o efeito da temperatura e a quantidade de polivinilpirrolidone (PVP). As temperaturas utilizadas foram 100, 120 e 140 °C. Estabeleceram-se três relações: de 0.00; 0.25 e 0.50 (% w/w) de PVP/AgNO3. As nanopartículas com tamanhos menores de 30 nm obtiveram-se em condições de 120 °C e 0.5 (% w/w) de PVP/AgNO3. As nanopartículas obtidas em concentrações de 10 e 20 ppm foram logo depositadas em tecidos de algodão, mediante a técnica "pad-dry-cure" (tecido curado e seco), com o objetivo de analisar suas propriedades contra a bactéria Gram positiva Staphylococcus aureus 25923. As provas mostraram que os tecidos de algodão com uma concentração de 10 e 20 ppm tinham boas propriedades bactericidas, devido à redução das colônias de bactérias por cima dos 98 %. Finalmente, levou-se a cabo um estudo de estabilidade do lavado dos tecidos impregnados com as nanopartículas de prata, e, além disso, utilizou-se um ligante acrílico durante o processo de impregnação. Os resultados obtiveram-se mediante análises bacteriológicas.
Palavras chave: Algodão, Bactericidas, Ligante, Nanopartículas de prata.
I. Introduction
Nowadays the nanotechnology development has experienced a considerable increase. According to statistics, around 30 % of the products using nanotechnology contain silver nanoparticles, which means that their field of action is important within this branch of products. Something interesting about silver nanoparticles is that they are required in low quantities, so their weight compared to other nanoparticles is lower 1.
Silver nanoparticles have some applications in electronics and chemistry, due to their electrical and thermal conductivity, chemical stability, and catalytic activity among others, which has made possible their use in paints, microelectronics, and medical imaging. In the environmental field, these nanoparticles have been of great help for water antibacterial treatment. Additionally, in medicine these nanoparticles have had a great repercussion because they can be used to obtain coating materials for medical devices, such as catheters or bandages 2,3.
On the other hand, silver nanoparticles are widely used in the textile area, where their incorporation provide wrinkle resistance and antibacterial properties, among others [4]. Referring specifically to its bactericidal properties, there are several clothing product lines using this new technology, such as sportswear with water repellency, washing durability, better thermal performance, and odor removal properties. Additionally, these tissues are used in medical clothing such as gowns, gloves, masks, etc., in order to avoid disease transmissions and premature wear of tissues 3.
Interest in the application of nanoparticles in the textile field has grown because certain microorganisms have increased their resistance to some antibiotics. Therefore, new control alternatives are studied, because textiles are in direct contact with human skin, making them more prone to diseases contagion 5. This technology has been applied mainly in cotton fabrics, due to their susceptibility to become nests for microorganism reproduction, since they are composed of natural fibers and absorb more moisture. Additionally, the technology has been applied on synthetic fabrics such as polyester and nylon, which have lower moisture absorption, static reduction, and improved water repellency compared to cotton 6. As mentioned before, the advantage of using nanoparticles is that they are only required in low quantities, which can be corroborated with the studies of Lee and Jeong 7, who indicated that with concentrations of 10, 20 and 30 ppm of silver nanoparticles impregnated in cotton fabric, the number of bacterial colonies could be reduced by 99.99 %.
Studying the addition of nanoparticles to textiles requires good adhesion, so that the properties acquired have the desired effect. Therefore, the use of binding agents is highly important because they can be a link between the textile and the nanoparticles, avoiding the loss of nanoparticles over time due to the use or washing. Among the available binders, there are those based on acrylates, butadiene, and vinyl acetate. The final requirements, the applications, as well as the cost should be considered in order to choose the type of binder 8.
Nowadays, there are studies on related topics such as those of El-Rafie et al. (9, who impregnated silver nanoparticles in cotton fabric at a concentration of 50 ppm, with and without 1 % of acrylic binder. According to their results (obtained by atomic absorption spectrophotometry), the silver content was 63.20 and 72.15 mg/kg respectively, indicating that the binder achieves greater adhesion of silver nanoparticles 9. Another example is the study of Gupta et al. (10, who, in order to determine the self-cleaning activity achieved by the fabrics, used nanoparticles of titanium dioxide and zinc oxide in cotton fabrics with percentages between 1 and 10 of acrylic binder, obtaining better results with the lowest percentage of binding agent.
This study aims at obtaining a cotton fabric with bactericidal properties. To achieve this, silver nanoparticles were synthetized and eventually added to the tissues; then, they were subjected to bacteriological analysis, with exposure to the Gram positive bacteria Staphylococcus aureus 25923. Subsequently, the fabrics solidity in respect to washing was studied to verify the adhesion of the nanoparticles to the fabrics using a binding agent, for which a new bacteriological analysis was performed.
II. Methodology
A. Synthesis
Silver nanoparticles were synthetized by the polyol method, in which silver ions were reduced. The reagents used were silver nitrate (AgNO3), polyvinylpyrrolidone (PVP) as stabilizing agent, and ethylene glycol (C2H6O2) as a solvent and reductant. PVP and ethylene glycol solutions were heated to 100, 120 and 140 ° C, considering 0, 0.25 and 0.50 (% w/w) of PVP/AgNO3. When the solution reached the desired temperature, a silver nitrate and ethylene glycol solution was added and allowed to react. The obtained solution was washed with acetone by centrifugation to achieve the nanoparticles precipitation.
B. Characterization of nanoparticles
A Brookhaven 90 plus dynamic light scattering equipment (DLS) was used to determine the size and dispersion of the nanoparticles. In addition, a FEI Tecnai G2 Spirit Twin transmission electron microscope (TEM) was used to establish the nanoparticles morphology.
C. Impregnation of nanoparticles in cotton fabrics
The pad-dry-cure method was used to impregnate the nanoparticles in cotton fabrics. Circular cotton samples of 4.8 cm diameter were treated with 10 and 20 ppm silver nanoparticle solution. The impregnation was carried out in two cases: In the first case, the fabrics were dipped separately into each of the mentioned solutions for a period of 10 minutes, after which the excess solution was removed from the fabric samples and subjected to a drying process at 90 °C for 10 minutes; finally, the samples were cured at 120 °C for 3 minutes. For the second impregnation case, an acrylic binder (Sennelier) consisting of a pure acrylic resin was used; this binder was added to the silver nanoparticle solution before dipping the fabric into 1, 3 and 5 % w/w of binding agent. The subsequent impregnation conditions were the same as those in the first case.
D. Bacteriological analysis of impregnated fabrics
The AATCC Test Method: We used the 100-2004 standard as a quantitative analysis of the number of formed microorganisms. We used the Gram positive bacteria Staphylococcus aureus 25923, in order to determine whether the fabric samples impregnated with the two different concentrations of silver nanoparticles had acquired bactericidal capacity.
Bacterial colonies reduction was calculated by equation (1):

Where A is the number of colonies in a sample with no treatment, and B is the number of colonies in a sample with treatment.
E. Washing of cotton fabrics
The fabric samples impregnated with silver nanoparticles were subjected to 10 washing cycles, in a standard laboratory equipment Launder-Ometer. The fabrics were placed into stainless steel containers with 150 ml of a 0.15 % w/w solution of water with detergent. The AATCC Test Method 61-2009 was used at a temperature of 49 (± 2) ° C.
III. Results and Discussion
We performed a total of nine tests with the conditions of temperature and weight ratio of PVP/AgNO3 stated in section 2. The nanoparticles effective diameter was determined by dynamic light scattering as shown in Table 1. The best result (smallest size) is shown in figure 1. A small particle size is important because it can facilitate its integration into the cotton fabric. On the other hand, the smaller the particles are, the greater is the covered surface area, and their bactericidal capacity, since they will have greater interaction with the microorganisms 11. In addition, according to the studies carried out by Lee and Jeong 7, when the particle size is small, there is a lower risk of skin irritation in the case of direct contact of nanoparticles with human tissues. Therefore, we used the polyol method, since it allows better control of the nanoparticles size and shape 12.

Both temperature and amount of PVP influenced the nanoparticle size; the higher the amount of PVP, the lower the size of the nanoparticle. These results agree with those obtained by Rosas and Ruiz 13, who indicated that a greater amount of stabilizing agent (PVP) allows a decrement in the particle size. This phenomenon occurs because the PVP coating of the nanoparticles prevents agglomeration.
Figure 1 shows a bimodal intensity curve versus the particle diameter. This is due to the solution polydispersity, since the capacity of the nanoparticles to disperse the incident light depends on their diameter. For this reason, those of larger size will present a greater intensity and vice versa 14.

Fig. 1
Effective diameter size of 39.5 nm. Sample prepared at 120 °C and 0.5 (% w/w) of PVP/AgNO3.
Another important factor is the nanoparticle stability, which depends on several factors, including the solution temperature and the amount of reducing agent used. This is due to the action of the Van Der Waals and Coulomb forces that act as attraction and repulsion, respectively, and even steric forces corresponding to the action of the stabilizing agent, as they produce a barrier preventing the nanoparticles from agglomerating, but also do not pull them too far apart 15-16.
Z potential is a fundamental parameter that measures the nanoparticles stability by indicating the intensity of attraction and repulsion forces among them. In this case, the stability is reflected in the charge value of the nanoparticles, and the mean value of the z potential, which was -28.49 (mV) (Fig. 2). As mentioned by Skoglund et al. (17, if the z potential is lower than 20 mV, the sample is considered unstable and prone to agglomeration and sedimentation; in this case, given that the value is greater than 20 mV, the sample is considered stable.

Fig 2
Z potential of silver nanoparticles. Sample prepared at 120 °C and 0.5 (%w/w) of PVP/AgNO3.
The transmission electron microscopy (TEM) the lack of agglomeration (Fig. 3). In addition, we micrograph showed two aspects of the nanoparticles: measured individual particle sizes using TEM (Fig. 4 first, the tendency to a spherical form, and second, and Table 2) 18.

Fig 3
TEM micrograph of the sample prepared at 120 °C and 0.5 (% w/w) of PVP/AgNO

Fig. 4
TEM micrograph with particle size measurement.

Particle size fluctuated between 15.4 and 39.9 nm, with an average of 26.2 nm. Sizes obtained with TEM micrographs will always have smaller diameters than those obtained by the dynamic light scattering (DLS), because TEM only considers the inorganic particle size, while DLS measures both the inorganic and organic part of the particle, in this case the particle and the coating agent (PVP) diameter 14.
Once the nine tests were completed, the one with the smallest effective particle diameter (39.5 nm according to DLS method) was chosen as the best. These nanoparticles were impregnated in the cotton fabrics, whose weight per area was 130 g/m2.
Scanning electron microscopy (SEM) was used to verify the presence of the nanoparticles in the cotton fabric. Figure 5 shows the fabrics with and without nanoparticles, and how the nanoparticles are dispersed in the tissues.

Fig 5
SEM Micrographs a) cotton fabric, b) silver nanoparticles in cotton fabric.
A bacteriological analysis was carried out on fabrics impregnated with 10 and 20 ppm of silver nanoparticles. These concentrations were used because other researchers, such as Zhang et al. (19 indicated the used of concentrations between 20 and 200 ppm of silver nanoparticles. Zhang et al. (19 subjected cotton fabric to the attack of the bacterium Staphylococcus aureus, and achieved reductions of the microorganism from 99.96 % to 100 %, so it can be concluded that with the lowest concentration (i.e., 20 ppm), a reduction of 99 % is already evident 19. Results showed that the cotton fabrics with the two treatments produced a reduction over 98 % in the number of colonies of the Gram-positive bacteria of Staphylococcus aureus 25923 (Table 3).

When comparing the two treatments with the untreated tissue, the decrease in the number of bacterial colonies is clearly demonstrated (Fig. 6 and 7). The bacterial reduction is due to the attack that the bacteria suffer from the silver nanoparticles; according to Siauw 20, the attack can be produced by three different routes: attack the bacterial respiration, the replication, or produce cell wall damage.
Fig 6
Untreated cotton fabric 130 g/m2.
Fig
7. Treated cotton fabric (130 g/m2) a) concentration of 10 ppm, b) concentration of 20 ppm.
In order to test the stability of the fabric to washing, we used cotton fabric samples of 130 g/m2 with the silver nanoparticles treatment of 10 ppm. Once we impregnated the samples, we subjected them to 10 washing cycles, following the AATCC Test Method 61-2009 standard. Subsequently, we performed a new bacteriological analysis on the fabric samples with and without nanoparticles. Results showed that there was no reduction of bacterial colonies after washing the fabrics, which clearly indicates the lack of adhesion of the treatment (Table 4).

Next, in order to improve the retention of the nanoparticles in the textile fabric, an acrylic binder was incorporated into the impregnation process, as mentioned in section 1.3. Values of 1, 3 and 5 % w/w were considered according to Gupta et al. (10, who considered the binder percentage in relation to the fabric weight in values between 1 and 10 %. Despite the authors used titanium dioxide and zinc oxide nanoparticles, the application principle and utility is the same. Table 5 shows the bacteriological analysis of impregnated fabrics with binding agent after 10 washing cycles.

The number of bacterial colonies in the fabric after washing decreased compared to the values in Table 4, indicating that the use of a binding agent decreases bacterial growth. The results also showed that as the binding agent percentage increased, there was a greater bacterial reduction. Therefore, the binder succeeded in creating the expected bond between the nanoparticle solution and the cotton fabric. This is because the binder is a film composed of a long chain of macromolecules that, when in contact with the nanoparticles and the fabric, manages to create a three-dimensional network that holds them together, and prevents the nanoparticles to be liberated in the washing process. It should be mentioned that these bonds could be formed thanks to the impregnation process, which is normally performed with heat or with changes of pH 8.
IV. CONCLUSIONS
Cotton fabrics with silver nanoparticles in low concentrations of 10 and 20 ppm showed a good reduction of bacterial growth, with values of 98.86 % and 99.94 %, respectively. The smallest effective diameter of silver nanoparticles obtained was 39.5 nm at 120 °C and 0.5 (% w/w) PVP/AgNO3. An acrylic binder is very helpful in the permanence of silver nanoparticles in cotton fabrics, as it was shown by the improvement in the reduction of bacterial growth by 52.68 % when using 5 % of binder, with respect to the weight.
ACKNOWLEDGMENT
Authors thank Dr. Alexis Debut, professor at the University of the Ecuadorian Armed Forces (UFA-ESPE), for his collaboration in the transmission electron microscopy analysis.
References
[1] B. Reidy, A. Haase, A. Luch, K. Dawson, and I. Lynch, "Mechanisms of Silver Nanoparticle Release, Transformation and Toxicity: A Critical Review of Current Knowledge and Recommendations for Future Studies and Applications," Materials, vol. 6 (6), pp. 2295-2350, Jun. 2013. DOI: http://doi.org/10.3390/ma6062295.
[2] I. Q. H. Tran, V. Q. Nguyen, and A.-T. Le, "Silver nanoparticles: synthesis, properties, toxicology, applications and perspectives," Adv. Nat. Sci. Nanosci. Nanotechnol.,vol. 4 (3), pp. 33001 33021, 2013. DOI: http://doi.org/10.1088/2043-6262/4/3/033001.
[3] A. Haider, and I. Kang, "Preparation of Silver Nanoparticles and Their Inwdustrial and Biomedical Applications: A Comprehensive Review," Adv. Mater. Sci. Eng., vol. 2015, pp. 1-16, 2015. DOI: http://doi.org/10.1155/2015/165257.
[4] T. Kirstein, Multidisciplinary Know-How for Smart-Textiles Developers. Cambridge, United Kingdom: Woodhead Publishing Limited, 2013. DOI: http://doi.org/10.1533/9780857093530.
[5] I. Perelshtein, G. Applerot, N. Perkas, G. Guibert, S. Mikhailov, and A. Gedanken, "Sonochemical coating of silver nanoparticles on textile fabrics (nylon, polyester and cotton) and their antibacterial activity," Nanotechnology, vol. 19 (24), p. 245705, Jun. 2008. DOI: http://doi.org/10.1088/0957-4484/19/24/245705.
[6] A. Wasif, and S. Laga, "Use of Nano Silver as an Antimicrobial Agent for Cotton," AUTEX Research Journal, vol. 9 (1), pp. 5-13, Mar. 2009.
[7] H. Lee, and S. Jeong, "Bacteriostasis and Skin Innoxiousness of Nanosize Silver Colloids on Textile Fabrics," Textile Research Journal, vol. 75 (7), pp. 551-556, Jul. 2005. DOI: http://doi.org/10.1177/0040517505053952.
[8] M. Iqbal, J. Mughal, M. Sohail, A. Moiz, K. Ahmed, and K. Ahmed, "Comparison between Pigment Printing Systems with Acrylate and Butadiene Based Binders," JASMI, vol. 2 (2), pp. 87-91, Jun. 2012. DOI: http://doi.org/10.4236/jasmi.2012.22016.
[9] M. El-Rafie, H. Ahmed, and M. Zahran, "Characterization of nanosilver coated cotton fabrics and evaluation of its antibacterial efficacy," Carbohydrate polymers, vol. 107, pp. 174 81, Jul. 2014. DOI: http://doi.org/10.1016/j.carbpol.2014.02.024.
[10] K. Gupta, M. Jassal, and A. Agrawal, "Functional Finishing of Cotton Using Titanium Dioxide and Zinc Oxide Nanoparticles," Research Journal of Textile and Apparel, vol. 11 (3), pp. 1-10, Aug. 2007. DOI: http://doi.org/10.1108/RJTA-11-03-2007-B001.
[11] K. Abou El-Nour, A. Eftaiha, A. Al-Warthan, and R. Ammar, "Synthesis and applications of silver nanoparticles," Arabian Journal of Chemistry, vol. 3 (3), pp. 135-140, Jul. 2010. DOI: http://doi.org/10.1016/j.arabjc.2010.04.008.
[12] N. L. Pacioni, C. D. Borsarelli, V. Rey, and A. V. Veglia, "Synthetic Routes for the Preparation of Silver Nanoparticles," Silver Nanoparticle Applications, 2015. DOI: http://doi.org/10.1007/978-3-319-11262-6_2.
[13] A. Ruíz-Baltazar, and G. Rosas, "Efecto de la concentración de agente surfactante (PVP) en el tamaño y distribución de nanopartículas de plata sintetizadas por el método de reducción química," in 7° Foro de Ingeniería e Investigación en Materiales, 2010, vol. 7, pp. 13-18.
[14] E. Tomaszewska, K. Soliwoda, K. Kadziola, B. Tkacz-szczesna, G. Celichowski, M. Cichomski, W. Szmaja, and J. Grobelny, "Detection Limits of DLS and UV-Vis Spectroscopy in Characterization of Polydisperse Nanoparticles Colloids," Journal of Nanomaterials, vol. 2013, pp. 1-10, Jun. 2013. DOI: http://doi.org/10.1155/2013/313081.
[15] V. Starov, Nanoscience: Colloidal and Interfacial Aspects. USA: CRC Press, Jun. 2010.
[16] A. Sileikaité, J. Puiso, I. Prosycevas, and S. Tamulevicius, "Investigation of Silver Nanoparticles Formation Kinetics During Reduction of Silver Nitrate with Sodium Citrate," vol. 15 (1), pp. 1-7, Jan. 2009.
[17] S. Skoglund, T. Lowe, J. Hedberg, E. Blomberg, I. Wallinder, S. Wold, and M. Lundin, "Effect of Laundry Surfactants on Surface Charge and Colloidal Stability of Silver Nanoparticles," Langmuir, vol. 29 (28), pp. 8882-8891, Jul. 2013. DOI: http://doi.org/10.1021/la4012873.
[18] C. R. Arroyo, A. Debut, A. V. Vaca, C. Stael, K. Guzmán, B. Kumar, L. Cumbal, Reliable Tools for Quantifying the Morphogical Properties at the Nanoscale, Biology and Medicine, vol. 8 (3), pp. 1-4, 2016. DOI: http://doi.org/10.4172/0974-8369.1000281.
[19] F. Zhang, X. Wu, Y. Chen, and H. Lin, "Application of Silver Nanoparticles to Cotton Fabric as an Antibacterial Textile Finish," Fibers Polym., vol. 10 (4), pp. 496-501, Aug. 2009. DOI: http://doi.org/10.1007/s12221-009-0496-8.
[20] W. Siauw, "Silver Nanoparticles: A Valuable Weapon in Microbial Warfare," Illumin, vol. XVII (II), 2011.
Cómo citar este artículo: